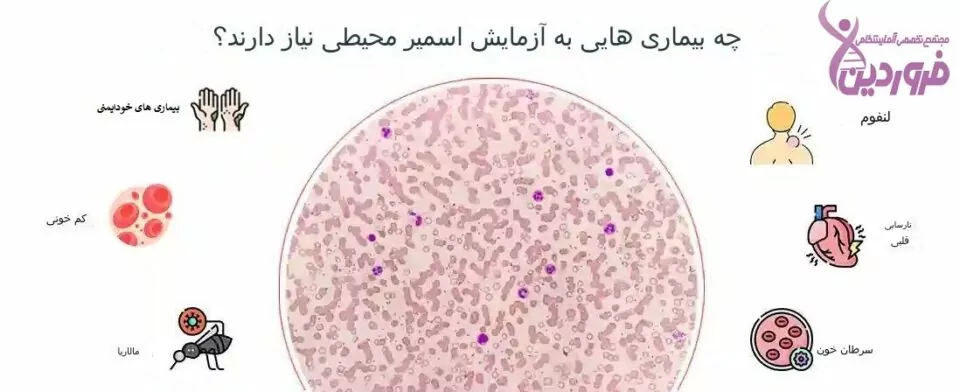
آزمایش اسمیر خون محیطی, آزمایشگاه فروردین

آزمایش اسمیر خون محیطی (PBS) چیست؟
آزمایش اسمیر خون محیطی تکنیکی است که پزشک برای بررسی گلبولهای قرمز و سفید خون و پلاکتهای بیمار استفاده میکند. بر خلاف برخی از آزمایشهای خون که توسط یک دستگاه تجزیه و تحلیل میشوند، پزشک، تجزیه و تحلیل را با نگاه کردن به سلولهای خونی زیر میکروسکوپ انجام میدهد.
برای پاسخ به این سوال که آزمایش لام خون چیست، باید گفت، پزشک ممکن است درخواست آزمایش اسمیر خون محیطی همراه شمارش کامل خون (CBC) را داشته باشد، یا اگر قبلاً CBC انجام شده باشد و فعالیت غیرطبیعی سلولهای خونی را نشان دهد، ممکن است آزمایش PBS درخواست شود. به عنوان مثال، نتایجCBC ممکن است نشان دهد که گلبولهای سفید، گلبولهای قرمز و یا پلاکتها غیرطبیعی باشند یا تعداد غیرطبیعی از هر نوع سلولی وجود داشته باشد. یک نمای میکروسکوپی از سلولها ممکن است به پزشک کمک کند تا دریابد چگونه و یا چرا سلولهای خونی غیرطبیعی به نظر میرسند و یا تعداد آنها غیرطبیعی است.
نتایج آزمایش اسمیر خون محیطی، الزاماً بهمنزلهی تشخیص نیست. پزشک بر اساس سابقه پزشکی، معاینه بالینی و نتایج آزمایشهای دیگر)مانند آزمایش (PBS، تشخیص نهایی را انجام خواهد داد.
چه شرایطی باعث میشود پزشک آزمایش اسمیر خون محیطی توصیه کند؟
در اینجا دلایل دیگری وجود دارد که چرا پزشک ممکن است آزمایش اسمیر خون محیطی را تجویز کند:
بیمار علائمی دارد که نشاندهنده اختلالات خونی بالقوه یا سایر شرایط است. پزشک میدانند که برخی از تغییرات سلولهای خونی یا پلاکتی با شرایط خاص مرتبط است. نتایج آزمایش PBS نیز الزاماً یک تشخیص نهایی نیست، اما به تصویری که پزشک برای تشخیص ایجاد میکند، کمککننده است.
آزمایش لام خون محیطی: چه نتایجی را میتوان از آن استخراج کرد؟
برای درک آنچه آزمایش PBS نشان میدهد، آگاهی از نقش سلولهای خونی و پلاکتها ضروری است. در این زمینه، تست اسمیر خون محیطی و تست اسمیر خون ابزارهای مهمی هستند که به تحلیل دقیقتر وضعیت سلولهای خونی کمک میکنند.
- گلبولهای قرمز: گلبولهای قرمز مسئول انتقال اکسیژن از ریهها به بافتهای بدن هستند. بافتها از اکسیژن برای تولید انرژی استفاده میکنند و در این فرآیند دیاکسید کربن تولید میشود. تست اسمیر خون میتواند به بررسی تعداد و وضعیت گلبولهای قرمز کمک کند تا اختلالات احتمالی شناسایی شوند.
- گلبولهای سفید:گلبولهای سفید بخشی از سیستم ایمنی بدن هستند و در برابر عفونتها دفاع میکنند. پنج نوع مختلف گلبول سفید وجود دارد که هرکدام به روشهای خاص خود با عفونتها مقابله میکنند. تست اسمیر خون محیطی به تحلیل دقیقتر گلبولهای سفید و شناسایی تغییرات غیرعادی در آنها کمک میکند.
- پلاکتها: پلاکتها به لخته شدن خون و جلوگیری از خونریزی کمک میکنند. تعداد کم پلاکتها ممکن است نشانهای از مشکلات جدی مانند سرطان، عفونت یا دیگر اختلالات باشد. با استفاده از آزمایش اسمیر خون میتوان وضعیت پلاکتها را بررسی و مشکلات احتمالی را شناسایی کرد.
آزمایش اسمیر خون محیطی نشان میدهد که موارد زیر وجود دارد یا نه:
- تغییرات در اندازه و شکل سلولهای خونی و پلاکت ممکن است نشانهای از یک اختلال خونی یا سرطان خون باشد.
- تغییرات در تعداد سلولهای خونی و پلاکتها ممکن است نشانهای از وقوع اتفاقی در مغز استخوان باشد که سلولهای خونی و پلاکتها را تولید میکند. تست اسمیر خون به تشخیص و پیشگیری از بیماریهای مربوط به مغز استخوان کمک میکند.
- تغییرات غیرطبیعی در هر یک از انواع مختلف گلبولهای سفید خون.
- علائمی که ممکن است در خون شما انگل وجود داشته باشد.
بیماریهایی که نیاز به آزمایش اسمیر خون محیطی دارند
پزشک از تست اسمیر خون محیطی برای تشخیص اختلالات خونی، سرطانهای خون و عفونتها استفاده میکند. این تست به بررسی تغییرات در سلولهای خونی کمک میکند و میتواند به شناسایی شرایطی که در آنها سلولهای مغز استخوان دچار جهش شده و به سلولهای سرطانی غیرطبیعی معروف به بلاست تبدیل میشوند، کمک کند. تست اسمیر خون اطلاعات دقیقتری در مورد وضعیت سلولهای خونی ارائه میدهد و در تشخیص موارد زیر کاربرد دارد:
- لوسمی: زمانی که سلولهای مغز استخوان دچار جهش شده و به سلولهای غیرطبیعی تبدیل میشوند که تعداد آنها از سلولهای خونی طبیعی بیشتر است، به این حالت سرطان خون گفته میشود. تست اسمیر خون محیطی میتواند به شناسایی این تغییرات کمک کند.
- سندرم میلودیسپلاستیک: این سندرم شامل سرطانهای ناشی از جهش در سلولهای بنیادی خون است. این جهشها ممکن است تولید گلبولهای سفید بالغ سالم، گلبولهای قرمز و یا پلاکتها را مختل کنند.
- کمخونی: زمانی که بدن فرد هموگلوبین کافی ندارد، دچار کمخونی میشود. تست اسمیر خون محیطی میتواند به شناسایی کمبود گلبولهای قرمز و علل آن کمک کند.
- نارسایی قلبی: تعداد بالای گلبولهای قرمز خون ممکن است نشانهای از سطوح پایین اکسیژن خون مرتبط با نارسایی قلبی باشد.
- لنفوم: سرطان سیستم لنفاوی که معمولاً از غدد لنفاوی شروع میشود. آزمایش اسمیر خون محیطی میتواند تغییرات در سلولهای سفید خون و تشخیص لنفوم را تسهیل کند.
- بیماریهای خود ایمنی: زمانی که سیستم ایمنی بدن به طور تصادفی به جای محافظت از بدن، حملاتی را به بدن انجام دهد. تعداد کم گلبولهای سفید ممکن است نشانه یک بیماری خود ایمنی باشد. تست اسمیر خون میتواند به شناسایی این اختلالات کمک کند.
نتایج آزمایش اسمیر خون محیطی: چه اطلاعاتی را به ما میدهند و چه معنایی دارند؟
پزشکان به دلایل خاص آزمایش اسمیر خون محیطی را سفارش میدهند. ممکن است CBC، نتیجه غیرطبیعی را نشان دهد و پزشک در حال انجام آزمایش برای کسب اطلاعات بیشتر باشد. ممکن است علائم خاصی وجود داشته باشد و این آزمایش به پزشک کمک میکند تا علت را تشخیص دهد. صرفنظر از این، آنها توضیح خواهند داد که چرا آزمایش اسمیر خون محیطی را توصیه میکنند و نتایج به چه معناست.
پرسشهای متداول
لام خون محیطی چیست و چه کاربردی دارد؟
لام خون محیطی (Peripheral Blood Smear) یک آزمایش میکروسکوپی است که به بررسی شکل و تعداد سلولهای خونی میپردازد. این آزمایش به پزشکان کمک میکند تا انواع اختلالات خونی، از جمله کمخونیها، لوسمی و سایر بیماریها را شناسایی کنند. در این آزمایش، قطرات کوچکی از خون روی لام شیشهای قرار داده میشود و پس از خشک شدن، به صورت میکروسکوپی بررسی میشود.
PBS در آزمایش خون چیست و چه اهمیتی دارد؟
PBS مخفف “Peripheral Blood Smear” است و به آزمایش لام خون محیطی اشاره دارد. این آزمایش اطلاعات ارزشمندی درباره نوع و تعداد سلولهای خونی ارائه میدهد. تجزیه و تحلیل نتایج PBS میتواند به تشخیص زودهنگام بیماریهای خونی کمک کند و برای برنامهریزی درمان مؤثر ضروری است.
آزمایش خون محیطی چیست و چه اطلاعاتی ارائه میدهد؟
آزمایش خون محیطی، که به عنوان آزمایش لام خون محیطی نیز شناخته میشود، یک روش تشخیصی است که برای بررسی و تحلیل اجزای مختلف خون، از جمله گلبولهای قرمز، گلبولهای سفید و پلاکتها استفاده میشود. این آزمایش میتواند به شناسایی اختلالات خونی، عفونتها و بیماریهای مزمن کمک کند. با تجزیه و تحلیل دقیق نمونه خون، پزشکان میتوانند وضعیت سلامت عمومی بیمار را بهتر درک کرده و درمانهای مناسب را تجویز کنند.